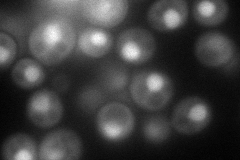
YGR230W
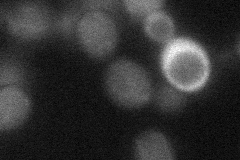
YGR230W
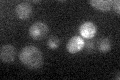
YGR230W

View description
Protein with some similarity to Spo12p; overexpression bypasses need for Spo12p, but not required for meiosis
Localization:
Intensity:
Fold change:
Significance:
-
C’ GFP library in SD

below threshold17.42 -
N' NOP1pr-GFP in SD
nucleus100.98 -
N' TEF2pr-mCherry in SD

nucleus36.026 -
N' NATIVEpr-GFP in SD

below threshold21.178 -
N' TEF2pr-VC and Cyto-VN in SD
below threshold26.0549 -
C’ GFP library in SD+DTT

cytosol17.91.02No -
C’ GFP library in SD+H2O2

cytosol15.70.9No -
C’ GFP library in Starvation Media
cytosol18.191.04No -
C’ GFP library on the background of Pup2-DaMP

below threshold -
C’ GFP library on the background of CCT mutant

below threshold15.73540.903084No
